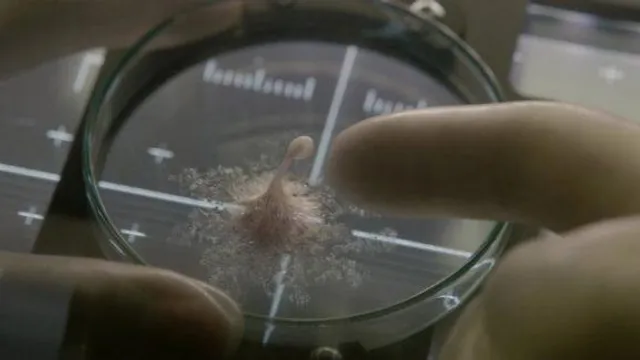

Доволі швидко у пресі "Життя" прозвали сумішшю "Гравітації" і "Чужого". Це враження справді досить стійке та помітне необзроєним оком. Стрічка здебільшого нагадує бійню, де загадкова істота потрохи нищить всіх членів команди. Їм, звісно, нікуди дітись: навколо вакуум, а везти цю чортівщину на Землю тим більше не варто. От космонавти і борються не так за своє життя, як за те, аби не дати на перший погляд милому марсіянчику перенищити нам півпланети. Але творці вирішили зробити фільм трохи розумнішим за звичайний бездумний трилер з чудовиськом, залучили консультантів-науковців і спробували внести туди ще й частку а-ля "Гравітація". Ніби й вдалось.
Наукові ляпи "Життя" легко можна нагуглити, але, насправді, вони не ріжуть око невимогливому глядачу. Завжди є категорія людей, які прагнуть максимальної реалістичності і нищать фільм навіть завдяки знанням фізики шкільного курсу. Так, "Життя" консультували-консультували і недоконсультували, але виглядає це все в цілому непогано.
Незважаючи на те, що в фільмі мало непередбачуваних сцен, режисеру Даніелеві Еспіносі вдається тримати увагу глядача від початку і до фінальних титрів. "Життя" підтримує напругу і таки віддає моторошністю через сцени смерті, яких у фільмі досить багато. Ну, зрештою, про те, що всі гинутимуть, здогадатись нескладно. Особливо після перегляду трейлера. А все так гарно починалось…
Сюжет фільму хороший тим, що герої не виглядають ні просто істеричним м'ясом, ні ідіотами, які постійно приймають дурні рішення і краще б мовчали. Їхні дії можна зрозуміти і якось для себе пояснити. Оскільки справу мали з чимось абсолютно новим і непередбачуваним, наперед знати як поведе себе перший в історії людства доказ позаземного життя складно. Ну хто чекав, що ця малеча принесе стільки проблем і виявиться такою розумною? Окей, хтось мав передбачити і такий варіант. Але продумали його і творці "Життя", просто ніхто не казав, що "План Б" передбачає виживання космонавтів на станції.
Трюк з кінцівкою хоч і читається, але додає азарту. Ну от можуть же зняти так, що хочеться написати негативний відгук, але не виходить. Бо ніби і цікаво було, і картинка класна, і ідею показали у вигідному світлі. Але... але цій стрічці бракує, власне, життя. Зачепити за живе смертю хоч когось із героїв фільму не дуже вдається, хоча такі спроби були. Це може бути страшно, чи гидко виглядати, але особливого співпереживання не викликає. У решті фільм непоганий.
Якщо ви більше прагнете емоцій і космосу, то, з останніх, дивіться романтичне "Пробудження". А якщо кортить розумних іншопланетян, які не ведуть себе як дикуни і не мають на меті всіх нас винищити, то зверніть увагу на "Прибуття". Але там шанси заплакати значно більші, ніж у всіх згаданих в цьому матеріалі стрічках.
Якщо ж вам кортить глянути щось на кшталт "Чужого", то "Життя" підійде ідеально. Фільм, суб'єктивно, вдався, про що свідчить і рейтинг 7,2 на IMDb.
Також у кіно: "Спліт": 24 особистості в одному Джеймсі Мак-Евої